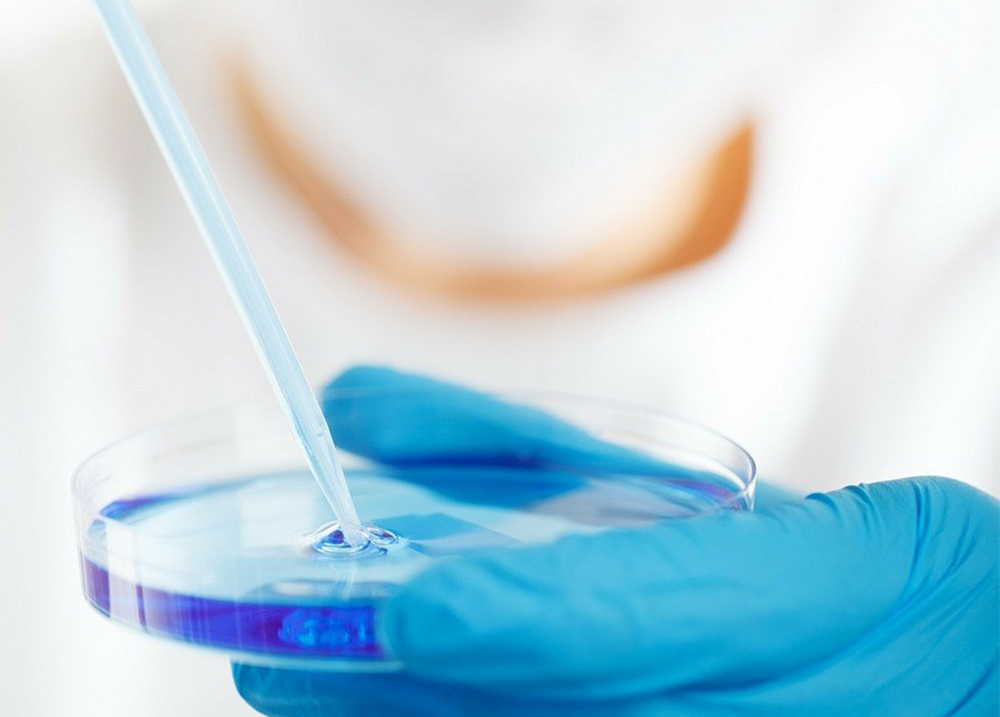

- 網站首頁
- 關于ADANA
- 公司簡介
- 公司歷程
- 榮譽證書
- 產品中心
- EMI酶解乳脂
- 蔗糖脂肪酸酯
- 復配穩定劑
- 可打發淡奶油的超強乳化穩定方案
- 新聞資訊
- 公司新聞
- 行業新聞
- 微信動態
- 科研創新
- 質量管理
- 技術交流
- 知識產權
- 技術案例
- 聯系我們
- 在線留言
- 首 頁
- 關于ADANA
- 公司簡介
- 公司歷程
- 榮譽證書
- 產品中心
- EMI酶解乳脂
- 蔗糖脂肪酸酯
- 復配穩定劑
- 可打發淡奶油的超強乳化穩定方案
- 新聞資訊
- 公司新聞
- 行業新聞
- 微信動態
- 科研創新
- 質量管理
- 技術交流
- 知識產權
- 技術案例
- 聯系我們
- 在線留言

首頁
首頁 電話咨詢
電話咨詢 聯系我們
聯系我們